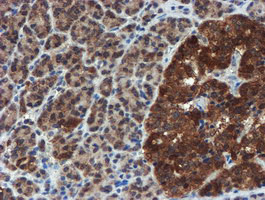
C17orf37 Antibody in Immunohistochemistry (Paraffin) (IHC (P))
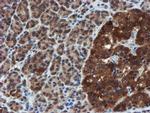
C17orf37 Antibody in Immunohistochemistry (Paraffin) (IHC (P))

Search
OriGene
C17orf37 Monoclonal Antibody (OTI2D2), TrueMAB™
{{$productOrderCtrl.translations['antibody.pdp.commerceCard.promotion.promotions']}}
{{$productOrderCtrl.translations['antibody.pdp.commerceCard.promotion.viewpromo']}}
{{$productOrderCtrl.translations['antibody.pdp.commerceCard.promotion.promocode']}}: {{promo.promoCode}} {{promo.promoTitle}} {{promo.promoDescription}}. {{$productOrderCtrl.translations['antibody.pdp.commerceCard.promotion.learnmore']}}
产品信息
TA800021
种属反应
宿主/亚型
分类
类型
克隆号
抗原
偶联物
形式
浓度
纯化类型
保存液
内含物
保存条件
运输条件
靶标信息
During the past decade, the role of the ERBB2(neu/HER2) oncogene as an important predictor of patient outcome and response to various therapies in breast cancer has been clearly established. The C35 (C17orf37) is a novel tumor biomarker abundantly expressed in breast cancer. Identification of shared tumor-specific targets is useful in developing broadly applicable therapies. The C35 gene is located on chromosome 17q12, 505nucleotides from the 3' end of the ERBB2oncogene, the antigenic target for trastuzumab(Herceptin) therapy. The chromosomal arrangement of the genes encoding C35 andERBB2 is tail to tail. The ORF 37 open reading frame encodes a 12-kDa protein of unknown function.
仅用于科研。不用于诊断过程。未经明确授权不得转售。
篇参考文献 (0)
生物信息学
蛋白别名: HBV X-transactivated gene 4 protein; HBV XAg-transactivated protein 4; MGC14832; Migration and invasion enhancer 1; protein C17orf37; protein C17orf37 homolog; Protein C35
基因别名: 1810046J19Rik; AI463380; C17orf37; C35; MIEN1; ORB3; RDX12; RGD1306682; XTP4
UniProt ID: (Human) Q9BRT3, (Mouse) Q9CQ86
Entrez Gene ID: (Dog) 480532, (Human) 84299, (Rat) 360617, (Mouse) 103742